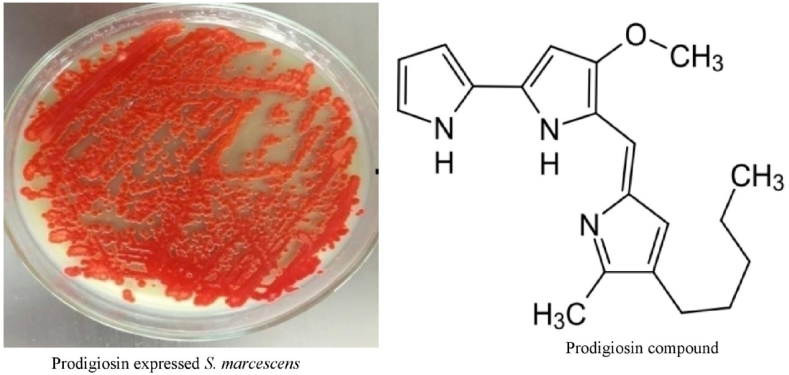
Fig. 1

Abstract
This research investigates the potentials of prodigiosin(PG) derived from bacteria and its formulations against triple-negative breast (TNB), lung, and colon cancer cells. The PG was extracted from S. marcescens using continuous batch culture, characterized, and formulated into lyophilized parenteral nanoparticles (PNPs). The formulations were characterized with respect to entrapment efficiency (EE), DSC, FT-IR, TEM, and proton nuclear magnetic resonance (1H NMR) spectroscopy. In vitro drug release was evaluated in phosphate buffer (pH 7.4) while acute toxicity, hematological and histopathological studies were performed on rats. The in vitro cytotoxicity was evaluated against TNB (MCF-7), lung (A-549), and colon (HT-29) cancer cell lines. High EE (92.3 ± 12%) and drug release of up to 89.4% within 8 h were obtained. DSC thermograms of PG and PG-PNPs showed endothermic peaks indicating amorphous nature. The FT-IR spectrum of PG-PNPs revealed remarkable peaks of pure PG, indicating no strong chemical interaction between the drug and excipients. The TEM micrograph of the PG-PNPs showed nano-sized formulations (20–30 nm) whose particles were mostly lamellar and hexagonal structures. The 1H NMR result revealed the chemical structure of PG showing all assigned proton chemical shifts. Toxicity results of the PG and its formulation up to a concentration of 5000 mg/kg showed insignificant vacuolar changes of hepatocytes in the liver, with normal renal medulla and cortex in the kidney. The PG and PG-PNPs inhibited the growth of breast, lung, and colon cell lines. The nano-sized lipid formulation (PG-PNPs) showed potential in PG delivery and cancer treatments.
Keywords: Serratia marcescens, prodigiosin (PG); Parenteral nanoparticles (PNPs); Cancer cell lines; Triple-negative breast cancer (TNBC); Lung cancer; And colon cancer
1. Introduction
Cancer, a disease of major healthcare concern, is estimated to afflict about one in four persons during their lifetime and is also responsible for one in every five deaths worldwide [1,2]. Globally, the health threat posed by breast cancers among younger women, especially in the reproductive age group (<50 years) has been widely reported to be triple-negative breast cancer (TNBC) [3,4]. This situation has prompted researchers and scientists to explore better drug delivery and treatment from natural products of plants, animals, and microbial origin to improve the quality of life and possibly, control the menace. Virtually, all cancers are caused by abnormalities of the gene-transforming cells [5]. These abnormalities could be a result of carcinogen intake through tobacco smoking, chemicals, radioactive materials, or other infectious agents [6]. Researchers are making relentless efforts aimed at discovering novel antineoplastic agents. Some compounds from plants and microorganisms have demonstrated good potential as sources of potent anticancer agents [7,8].
Prodigiosin (PG) is a red-pigmented compound that belongs to prodiginines of tripyrolic acid mainly produced by S. marcescens and some species of bacteria like Vibrio psychoerythrus, Streptoverticillium rubrireticuli and other eubacteria [9]. PG also has some other important biological activities such as anticancer on TNBCs [10,11], antiproliferative activity [12], immunosuppressive [13], antioxidant [14], antimicrobial [15], and anti-malarial [16] activities. Some of these species of S. marcescens and other enteric bacteria can hydrolyze protein by fermentation and also, protect hosts against some diseases by expressing these active secondary metabolites such as PG [17]. Chemically, PG belongs to a group of pigmented compounds known by their pyrrolyl dipyrromethene skeleton that contains a moiety of 4-methoxy,2-2-bi-pyrrole ring system [18]. The linear derivatives are prodigiosin and undecyl prodigiosin, while cyclic derivatives include streptorubin B, cyclo prodigiosin, and cyclononylprodigiosin [19,20]. The pyrrolic ring A, ring B, and ring C are regarded as three forms of prodigiosin pyrrolic rings. Prodigiosin also exists in two different geometric isomers of trans (α) and cis (β) depending on the pH of the production and extraction solution as the trans form usually protonates more easily than the -cis state [21]. PG is an anticancer drug of natural origin. It has shown anticancer activity by its pro-apoptotic property against the proliferation of cancer cells through the cleavage of the active amine group into the intracellular cells which inhibits the proliferation of cells. This mechanism of action of prodigiosin is through induced cellular stresses, which include the vulnerability of intracellular pH changes [22], DNA damage response activation [23], and responsive cell cycle arrest, leading to apoptosis [24]. Researchers had earlier attempted to deliver PG through poly (N-isopropyl acrylamide)-based hydrogel implants against cancer but were unsuccessful due to the temperature of the swelling environment [25,26]. Considering the biological activities, solubility profile and other physicochemical properties of PG, the formulation of PG into pharmaceutical dosage form through lyophilization or spray drying will go a long way to bring to bear the medicinal importance and potential of PG. This research tends to develop prodigiosin parenteral nanoparticles (PG-PNPs) and test its potentials against cancer cells. This nanoparticulate system is believed to be more accurate and targeted in the delivery of a correct amount of drugs to appropriate sites of action without interference with other organs and can permeate the blood-brain barrier [27]. PG parenteral nanoparticulate delivery system was chosen to maximize its therapeutic effect and reduce toxicity. Consequently, this study aimed to formulate prodigiosin-based parenteral nanoparticles (PG-PNPs) for targeted drug delivery against TNBC, lung, and colon cancers. Also, to characterize and evaluate its cytotoxicity profile.
2. Materials and methodology
2.1. Materials
Prodigiosin (PG) was extracted from S. marcescens and purified using column and high-performance liquid chromatography, Polysorbate 20 (Croda Inc, India), Lipoid E80S, and Lipoid SPC3 (Lipoid, India). Similarly, the breast cancer cell line (MCF-7, ATCC), human lung cancer cell line (A-549, ATCC), and colon cancer cell line (HT-29, ATCC) were collected from the tissue bank unit of the Advanced Centre for Treatment, Research and Education in Cancer (ACTREC), Tata Memorial Centre, Navi Mumbai, Maharashtra, India. Adriamycin (Emcure Pharmaceuticals Limited, Pune, India). All other chemicals and reagents were of analytical grades. Table 1 contained the PG-PNPs formulation formula.
Table 1.
Formulation of prodigiosin.
| Excipient Name | Qty in mg/mL | Qty in mg/vial (2.5 mL) | Qty per batch (mg/100 mL) |
|---|---|---|---|
| Prodigiosin (PG) | 4.0 | 10 | 400 |
| Polysorbate 20 | 4.8 | 12 | 480 |
| Lipoid E80S | 6.0 | 15 | 600 |
| Lipoid SPC3 | 8.0 | 20 | 800 |
| Disodium hydrogen phosphate anhydrous | 1.0 | 2.5 | 100 |
| Sodium dihydrogen phosphate monohydrate | 1.2 | 3 | 120 |
| Ethanol | 0.4 | 1 | 40 |
| Water for Injection qs to | 1.0 | 2.5 | 100 |
Batch Size: 100 mL (40 vials 2.5 mL).
2.2. Methods
2.2.1. Production of PG from S. marcescens
The pure culture of S. marcescens was grown in large masses on a sterile peptone glycerol agar (PGA) using a surface spread agar plate [25]. This was repeated on several numbers of Petri dishes of up to 100 culture plates and incubated in dark conditions as required for the growth of the organism at 30 oC for 48 h.
2.2.1.1. Extraction and concentration of PG from S. marcescens
The surface culture method of PG extraction was adopted [25]. The mass culture of the S. marcescens on different PGA media plates was scooped into 100 ml of absolute ethanol (FINAR® Gujarat, India), and agitated vigorously to extract the red pigment into the ethanol as a soluble solvent [12]. The ethanolic PG solution extracted from S. marcescens was subjected to further purifications using rotary evaporation (BUCHI 011, Laboratorums®, Switzerland) and column chromatography with 2000W mesh silica gel (BDH Chemicals, England) which was used as the stationary phase, while the mobile phase was a mixture of ethyl acetate, chloroform and methanol (2:1:1) respectively.
2.2.2. Formulation of PG-parenteral nanoparticles (PG-PNPs)
PG-PNPs were formulated using a high-speed homogenization method [28]. Two different aqueous and lipid solutions were prepared. The lipid phase was first melted at 40 °C on a magnetic stirrer hot plate and thereafter, 400 mg of PG was dissolved in 40 ml ethanol and incorporated into the lipid matrices. The PG-lipid was mixed on a magnetic stirrer and later the ethanol was evaporated using a rotary evaporator. The aqueous phase (phosphate buffer pH 7.4) was transferred into the melted lipid film and immediately mixed with a high shear mixer at 6000 rpm using a rotary stator mixer (ACE machinery, Zhejiang, China) for 10 min at 25 OC and later homogenized in a high-pressure homogenizer (Avestin, Canada) at 20,000 PSI for 20 min to form the PNP nanoparticulate dispersion. The PNPs with and without PG (loaded and unloaded lipid nanoparticles) were formulated and thereafter filled into glass vials equivalent to 10 mg (2.5 mL) and finally, freeze-dried using a Freeze dryer (Virtis Genesis, SP Scientific, USA). Thereafter, the lyophilized PG-PNP and PNP vials were sealed with a rubber stopper, capped with aluminum, and stored under dark conditions at room temperature.
2.2.3. Determination of particle size and zeta potential
The hydrodynamic particle size and the zeta potential of the PG-PNPs after reconstitution was measured using a Nano-ZS zeta sizer equipped with Zeta sizer software v6.34 (Malvern Instruments, United Kingdom) at 25 °C. A 20 mg of PG-PNPs powder was dispersed in 5 ml distilled water and thereafter vortexed to obtain a homogenous solution while the undissolved particles were removed through a refrigerated centrifuge (KUBOTA 5922, Thailand) at 10,000 g for 20 min at 25 °C. The particle size and zeta potential were determined immediately after obtaining the supernatant from the centrifugation.
2.2.3.1. Entrapment efficiency (EE) and drug loading capacity (DLC)
The entrapment efficiency (EE) of PG-loaded PNPs was determined by ultrafiltration using spectrophotometry [29]. A 1 g quantity of the formulated PG-NPs was weighed into a 100 ml volumetric flask. A 10 ml volume of 80% ethanol was added, mixed thoroughly, and sonicated for 20 min. The solution was further diluted with the same solvent and then filtered. The drug content was determined using a UV visible spectrophotometer (Jasco PU-2089 Plus, Japan) at a predetermined wavelength of 535 nm and compared with the theoretical content in the PG-PNPs. The entrapment efficiency (EE) and drug loading capacity (DLC) were obtained using equations (1), (2)):
| (1) |
| (2) |
2.2.3.2. Fourier transform infrared (FT-IR) spectroscopy
The equipment was equilibrated for 30 min after which appropriate parameters were set up by the spectra manager. A 2 mg quantity of the dried formulated samples of PG-PNPs was placed on the ATR crystal (ZnSe) and the screw of the ATR unit tightened clockwise until it touched the sample. The upper cabinet was closed to measure the sample spectra through the computer monitor. The same process was conducted on the PG-PNPs, PNPs, and PG. FT-IR spectra between 4000 and 400 cm−1 were determined after an accumulation of 16 scans using Spectrum One (PerkinElmer, MA, USA).
2.2.3.3. 1H -NMR analysis
The proton nuclear magnetic resonance (NMR) was conducted. The solvent exchange was carried out by adding 10 mL of aqueous PG-PNPs (0.48 w/v%) into acetone to reach a 15:1 (v/v) acetone and water ratio. The resultant sample was recovered as a precipitate after centrifugation (5000 rpm, 10 min), and the supernatant was discarded. The PG-PNPs were re-suspended in 50 mL of acetone and centrifuged again using the same conditions (5000 rpm, 10 min), discharging the supernatant. This was done repeatedly 3 times. A 0.1 g of PG-PNPs was suspended in 1 mL of deuterated water (D2O) to form a suspension, followed by heating at 30 °C under vacuum pressure for 2 h to remove the remaining acetone. The sample was kept under cover overnight using porous tissue paper under ambient conditions before NMR analysis. 1H NMR was done using Bruker NMR spectrometer, (Ultrashield Plus 700, USA) at 800 MHz using 5 mm CPTCI 1H–13C/15 N/D Z-GRD probe. 1H NMR spectra were obtained at 303 K in deuterated oxide (99.9% D) as a solvent with standard parameters using 16 scans and 2 dummy scans) and PG (64 scans and 16 dummy scans). For comparison, a 1H NMR spectrum of freeze-dried PG-PNPs dissolved in 2% deuterated acetic acid (CD3COOD) in D2O was obtained using the same parameters described previously.
2.2.3.4. Differential scanning calorimetry (DSC)
The DSC thermograms of the samples were determined using DSC Q2000 (TA Instruments, USA). A 2 mg of each of the samples was measured into an aluminum pan. The pans were subjected to a pan crimper Press (PerkinElmer, USA) and sealed hermetically. The experiment was conducted from 30 to 450 OC on a heating and cooling mode from 450 to 30 °C at a constant rate of 10 °C/min with a constant injection of nitrogen at 50 ml/min.
2.2.3.5. Transmission electron microscopy (TEM)
The morphological features of the PG and formulations were determined using transmission electron microscope (Jeol Model JM 2100, Japan). About 8 μL of 0.1 mg% PG-PNPs in 70% ethanol suspensions and pure PG were deposited into glow-discharged carbon-coated TEM grids (200-mesh copper, formvar-carbon, Ted Pella Inc., Redding, CA) and the extra liquid was removed using filter paper by blotting process. The samples were stained negatively using 2% uranyl acetate solution for 5 min and blotted with Whatman filter paper to remove the excess staining solution after which they were allowed to dry under ambient conditions. Thereafter, the samples were observed under a transmission electron microscope (Philip CM12) at an accelerating voltage of 100 kV.
2.2.4. In vitro PG release
The in vitro PG release was conducted in a single dissolution medium (phosphate buffer solution, pH 7.4) using dialysis bag by constant magnetic stirring method (Kenechukwu et al., 2017). This protocol was used to measure the PG release from PG-PNP (containing 50 mg PG) and compared with pure PG (25 mg). Firstly, PG-PNPs formulation (0.5 g/5 mL PBS pH 7.4) was first dispersed into a pretreated dialysis membrane tubing (Cellu.Sep H1 MWCO: Nominal 2000 g/mol: Membrane filter Products, Inc., Texas 78155, USA) and both sides of the membrane tube were closed with thread to prevent leakage. The semi-permeable membrane containing sample suspension was then tied to the retort stand, and suspended into the test tube (15 cm length/1.8 cm width) containing both 20 ml PBS and bar magnet respectively. The setup tube was then, fixed into a preheated 500 mL flask (Pyrex) containing 400 mL distilled water placed on the magnetic hot plate and stirred at 100 rpm. The entire system was maintained at 37 °C throughout the study. A sample aliquot of 5 mL was manually withdrawn and replaced with an equal volume of fresh medium at predetermined time intervals (0.5, 1.0, 2.0, 3.0, 4.0, 5.0, 8.0, 12.0, and 24.0 h). The same process was applied to PG alone. The sample aliquots were analyzed by UV spectrophotometer (Schimadzu Corp, UV-19001, Japan) for drug content at 535 nm. The cumulative PG release (∼50 mg = 100%) was calculated using the calibration curve of PG in PBS pH 7.4. Each experiment was performed in triplicate, and the average values and standard deviations were determined and reported.
2.2.5. Modified acute toxicity test
A modified acute toxicity study of the PG and PG-NPs was carried out in Wistar rats (50–80 g) using varying doses of the extract (10, 100, 1000, 2900, and 5,000 mg/kg body weight). The experimental animals were given access to feed and water intake ad libitum. All experiments involving animals were done following the National Institute of Health (NIH) guide on the care and use of laboratory animals (Pub No: 85-23 Revised 1985). The study was approved by the India Animal Ethical Committee (SSDJ/IAEC/20–21/01). The care and maintenance of all the animals were ensured following the approved guidelines of CPCSEA (Committee for the Purpose of Control and Supervision of Experiments on Animals). The doses used were administered intraperitoneally to male and female animals except for the control group, and observed for morbidity and mortality daily for 7 days. The experimental and control groups were bled through retro-orbital plexus and later sacrificed to harvest the liver and kidney for both hematology and histopathology studies. Hematological parameters were evaluated on the blood for; packed cell volume (PCV), total white blood cell count (WBC), red blood cell count (RBC), and hemoglobin concentration (HB), while pathological changes in the liver and kidneys were examined histo-pathologically.
2.2.6. Cell preparations
The breast cancer cell line (MCF-7, ATCC), human lung cancer cell line (A-549, ATCC) and colon cancer cell line (HT-29, ATCC) were obtained and thawed for in vitro anticancer evaluation. The cell lines were cultured in RPMI 1640 medium (HiMedia, Mumbai, India) supplemented with 10% fetal bovine serum (Sigma-Aldrich, St. Louis, MO, USA), L-glutamine 2 mM, penicillin 100 UI/mL and streptomycin 100 μM. Using CO2 incubator, four different inoculated microliter plates were incubated at different conditions of 37 °C, 5% CO2, 95% air and 100% relative humidity for 24 h before the addition of adriamycin (ADR), PG, PG-PNPs and PNPs formulation. The cancer cells were passaged at regular intervals to ensure reproducible behaviour and to maintain their health status. The seeding density of the cell culture was varying continuously until a consistent growth rate was achieved. Hemocytometer was used in determining the cell’s viability and count for the appropriate number of live cells used in the studies employing the trypan blue exclusion method.
2.2.6.1. In vitro cytotoxicity evaluation of PG, PG-PNPs, and adriamycin (ADR)
The in vitro anticancer evaluation of the PG, PG-NPs, and ADR against the cancer cell lines was done using the reverse transfection method [30,31]. This process involves transfecting and plating the cells simultaneously. The cell lines were subcultured in RPMI 1640 medium (Cytiva, USA) which 10% fetal bovine serum (Cytiva, USA) and 2 mM L-glutamine (ATCC, USA). In the evaluation experiment, cells (5 × 103 cells/well) were inoculated into microliter plates (96 wells) of 100 μL. After cell inoculation, the microliter plates were incubated in CO2 humidified Incubator (Thermo Fisher Scientific, Heracell VIOS, UK) at 37 °C, 5% CO2, 95% air, and 100% relative humidity for 24 h before drug and PG formulations addition. Subsequently, PG (100 mg) and PG-PNPs (100 mg) were dissolved in 10 ml DMSO and sterile water for injection respectively, the solution was further diluted to 1 mg/ml using the same sterile water and then frozen, before use. An aliquot of frozen concentrate (1 mg/ml) was later thawed and diluted to 100, 200, 400, and 800 μg/ml with a complete medium containing test PG, PG-PNPs, and PNPs respectively. A 10 μl each of the sample preparation was added to the appropriate microtiter wells already containing 90 μl sterile RPMI medium, having final concentrations of 10, 20, 40, and 80 μg/ml. The sample containing plates were then incubated in CO2 under 5% CO2 at 37 °C for 48 h and the assay was terminated by the addition of cold trichloroacetic acid (TCA), (Loba Chem 107 Mumbai, India). The cells were fixed in situ by the addition of 50 μl of cold TCA (10% w/v) and incubated for 60 min at 4 °C. The supernatant was discarded and then the plates were washed five times with sterile water and allowed to air dry. A 50 μl of ADR solution 0.4% (w/v) in 1% acetic acid was inoculated into each of the appropriate well plates, and then incubated for 20 min at 25 °C. The unbound stain cells were recovered and the residual dye was removed by washing five times with 1% acetic acid. The cell plates were air dried and subsequently, the bound stain was eluted using 10 mM Trizma base. The absorbances of the preparations were recorded using a Varioskan Lux plate reader (Thermo Scientific, USA) at 540 nm with 690 nm standard wavelength. The percentage of cell inhibition was determined on the test plates relative to the control sample plates. Also, the image of the cell morphologies and structures were taken using Nikon Inverted Microscope Eclipse Ti–S (Melville, NY, USA) with a magnification of 20X, with Eclipse Image processing software NIS-Elements.
Percentage growth inhibition was calculated as:
| [Ti/C] x 100% | (3) |
Where (C) is the control growth, and (Ti) is the test drug growth inhibition.
2.2.7. Data analysis
All in vitro data were analyzed using SPSS software (version 23) by one-way ANOVA and all the figures were illustrated by Graph-Pad Pad Prism software (version 8.0) and OriginPro (version 8.5) (see Fig. 1).
Fig. 1.
Serratia marcescens expressed prodigiosin.
3. Results and discussion
3.1. Percentage yield
The formulated PG-PNPs and PNPs samples depicted in Fig. 2, shows that the sample and the formulations were pinkish and amorphous powder after lyophilization with a percentage recovery of 97.1 and 97.8% respectively. This could be an indication that the formulation protocols and excipients were good and compatible (see Table 1).
Fig. 2.
The PG-PNPs and PNPs formulations.
3.2. Entrapment efficiency and drug-loading capacity (LC)
The EE and DLC of the PG-PNPs as shown in Table 2 indicated that the PG-loaded nano-sized formulation had good EE and DLC.
Table 2.
Physicochemical properties of PG-loaded PNPs.
| Formulation code | Drug content (%) | Entrapment efficiency (%) | Loading capacity (mg API/200 mg excipients) |
|---|---|---|---|
| PG-PNPs | 91.4 | 87 | 28.6 |
3.3. Fourier transform infrared (FT-IR) spectroscopy
The PG and lipids interactions were observed by FTIR spectroscopy and the results shows a noticeable broadband in the spectrum of pure PG (Fig. 3) between 2925 and 3000 cm−1 caused by hydrogen bonding from C–H and aromatic amine (N–H) stretching. Similarly, the peak at 2848.35 cm−1 was due to methoxy stretching (CH3–O), while the peaks observed at 1649.98 cm−1, 1195.65 cm−1, and 1040.41 cm−1 were produced by C=C stretching, ester C–O–C and C–O stretching respectively. Blank PNP exhibited peaks due to lecithin, polysorbate 20, and other excipients. The above-mentioned peaks recorded in PG spectra were very visible in the FTIR of the PG-PNPs. The FTIR of PG-PNPs shows characteristic peaks at 2946.25 cm−1 due to N–H stretching; O–H and N–H stretching produced a peak at 2467.79 cm−1; while the peak at 2823.56 cm−1 was due to N–H bending and as well C–H stretching. Methoxy, and methoxy stretching (CH3–O) yielded a peak at 2851.24 cm−1, while the peaks seen at 1635.62 cm−1 were due to C=C stretching in addition to ester C–O–C and C–O stretching, respectively.
Fig. 3.
The FT-IR (A) and NMR (B) spectra of prodigiosin (PG), PG-PNPs and PNPs samples.
3.4. Proton nuclear magnetic resonance (1H NMR) spectroscopy
The NMR spectra in Fig. 3 shows some prominent assigned chemical shift values for PG. Typically, upfield chemical shift values, δ of 1.5–2.39 ppm were due to NH and CH2 side chain of PG. The three –CH3 were assigned δ values of 0.88, 2.68, and 3.87 ppm; the δ value was 3.87 due to the influence of the –O-C- compared with –C-C. Two signals of δ 4.22 and 4.68 ppm were due to –N-H of the two pyrrole rings. Other downfield δ values of >5 ppm were due to the aromatic or olefinic protons of PG.
3.5. Differential scanning calorimetry (DSC)
Fig. 4 shows the DSC thermogram of the PG with a melting point well-defined by a broad endothermic peak at 195 °C. However, the admixture of the PNPs and PG in the PG-PNPs formulation shows a broad endothermic peak at 250 OC. Similarly, the PNPs had one endothermic peak at 190 °C followed by an amorphous halo at 220 °C, which correspond with the energy required to melt the lipid excipients in the PG-PNPs formulation. The observed widening peaks confirm the successful incorporation of the PG into the lipid vesicles leading to increased aqueous solubility. The thermograms suggest the amorphousness of the PG and PG-PNPs as a successful system for the delivery of PG leading to its increased aqueous solubility.
Fig. 4.
The DSC and TEM of PG and PNPs: The DSC thermograms of PG, PG-PNPs and PNPs physical mixture.
3.6. Transmission electron microscopy (TEM)
The transmission electron micrographs of the PG-PNPs, PNPs, and PG presented in Fig. 4 shows show the morphological structures of the samples, which revealed the internal, and microstructure of the formulated samples at 50 and 100 nm. The PNPs formulated with the PG drug shows evidence of coarse (large) microstructures when compared with the discrete (lamellar structures) of the PG-PNPs, which were more amorphous than the formulated blank PNPs. The Cryo-TEM morphological structure shows PG as a shrunk and melted material whereas the PNPs had lipidcles like and PG-PNPs had dense hexagonal amorphous formation.
3.7. In vitro drug release
The percentage release of PG from the parenteral nanoparticles (PNPs) as depicted in Fig. 5 shows the maximum release of 56.7% at 6 h, while the PG itself released up to 9% within the same period. However, the percentage release of both pure PG and PG-PNPs formulation was significantly improved with a significant (P < 0.05) increase in % PG-PNPs with 47.96 ± 0.0042, which is a good indication that PG delivery can be enhanced through a lipid drug delivery system.
Fig. 5.
A is the percentage release through in vitro dissolution of prodigiosin (PG) and PG from PG-PNPs in pH 7.4 phosphate buffer solution. B. Hematological parameters of pack cell volume (PVC), haemoglibin (HB), white blood cell (WBC) and red blood cell (RBC) of rats after taken PG and PG-PNPs at different doses.
3.8. Modified acute toxicity test
Modified acute toxicity of both the pure PG and PG-PNPs was evaluated using their effect on the hematology and histopathology of the liver and kidney.
3.8.1. Effect of PG and PG-PNPs on hematological parameters
The hematological parameters are shown in Fig. 5b for the modified acute treatment with 10–5000 mg/kg PG. At 5000 mg/kg, there was an induced significant (P < 0.05) rise in the RBC of 1.10 ± 0.32 × 109/L in comparison with the control. Similarly, at 1000 mg/kg, there was a significant (P < 0.05) rise in WBC counts of 14.15 ± 0.38 × 109/L when compared with the control. Also, a significant (P < 0.05) increase in % PCV with 38.3 ± 0.42, 39.5 ± 0.38, and 38.0 ± 0.21 for 5000 mg/kg PG, 10 mg/kg for PG-PNP and 5000 mg/kg for PG-PNPs respectively were observed in comparison with the control. In contrast, the PCV, HB, RBC, and WBC counts were significantly reduced with 1000 mg/kg b.w. for the PG as compared to the negative control group. Moreover, the PG-PNPs treatment group shows a significant increase in PCV, HB, R, BC, and WBC count with the administration of 10 and 100 mg/kg b.w. doses. The PCV result shows the percentage and hematological parameters indicating anaemia when the body system decreases its production of red blood cells below 30% or increases its destruction of red blood cells. HB is a protein molecule in red blood cells that carries oxygen from the lungs to the body's tissues and returns carbon dioxide from the tissues’ blood with the ranges of 8.6–15.38 g/dL in a rat. The hematological results obtained shows the safety of the PG and its PG-PNPs at concentrations up to 5000 mg/kg.
3.8.2. Histopathology
3.8.2.1. Effects of PG and PNPs on the liver
Histological examinations of liver sections of rats administered with graded doses of PG and PG-PNPs (Fig. 6) shows a normal architecture liver with a normal appearance of the central vein and hepatic sinusoids lined with endothelial and macrophages formed when compared with the controls. The normal lobular architecture of the liver was not affected; hepatocytes and macrophage formations also appeared normal. However, there was no treatment-induced related change in both appearance and diameter of hepatic sinusoids, as well as in central and portal veins.
Fig. 6.
Histopathology of liver and kidney sections of the animals treated with both PG at different concentrations A1 (10 mg/kg), A2 (100 mg/kg), A3 (1000 mg/kg), A4 (2900 mg/kg), A5 (5000 mg/kg) and A6 (Normal saline). Liver sections of groups treated with PG-PNPs; B1 (10 mg/kg), B2 (100 mg/kg), B3 (1000 mg/kg), B4 (2900 mg/kg), B5 (5000 mg/kg) and B6 (control). Kidney sections of groups treated with PG; A1 (10 mg/kg), A2 (100 mg/kg), A3 (1000 mg/kg), A4 (2900 mg/kg), A5 (5000 mg/kg) and A6 (control). Kidney sections of groups treated with PG-PNPs; B1 (10 mg/kg), A2 (100 mg/kg), B3 (1000 mg/kg), B4 (2900 mg/kg), B5 (5000 mg/kg) and B6 (control). [H and E x 40].
3.8.2.2. Effects of PG and PNPs on the kidneys
The histopathological and microscopic examination of kidney sections of rats administered with graded doses of PG and PG-PNPs (Fig. 6 A1-5; Fig. 6 B1-5) for single administration at intraperitoneal doses indicated no histopathological changes as compared to those of the controls. The kidney sections of all the groups shows normal renal medulla and renal cortex comprising the glomerulus (G) and renal tubules with associated interstitial spaces. The renal histology of both control and tests treated animals exhibited normal features: intact glomerular and tubular structures. The capillary tufts and size of the Bowman’s space appeared normal.
3.9. Cytotoxicity tests
3.9.1. Cytotoxicity activity of PG and PG-PNPs on MCF-7 TNB cancer cell line
The cytotoxicity activity of PG, PG-PNPs, and ADR on MCF-7 TNB cancer cell line as depicted in Fig. 7 shows percentage inhibition of the cells treatment with PG, PG-PNPs respectively, also ADR as a controlled drug. The PG at MCF-7 PG-10 μg (65.2%), PG-20 μg (86.4%) and MCF-7 PG-40 μg/ml (100%) caused cell rupturing leading to growth inhibition while MCF-7 PG-80 μg (100%) caused the total rupture of the cells when compared with the effect of ADR 40 μg/ml (100%) in MCF-7 inhibition. Similarly, the MCF-7 PG-PNPs-10 (28.6%), 20 (31.0%), 40 (36.1%), and 80 μg/ml (43.2%) shows cell growth inhibition through the rupture of the cell when compared with the untreated cells. In addition, Fig. 7 shows the cell growth inhibitions as observed in the cell rupture and morphologies with a significantly reduced number under the confocal microscope at different concentrations (MCF-7 - 10, 20, 40, and 80 μg/ml) when compared with ADR at the same concentrations. For the cells treated with blank PNPs and untreated cells, there was no inhibitory effect on the cell viability with no detectable cytotoxicity by the treatment concentrations. The PG and PG-PNPs had comparable cell viability to those of reference ADR drugs and blank PNPs.
Fig. 7.
The percentage cell inhibition of human MCF-7 breast cancer cell viability together with cell morphology after exposures with PG, PNPs, PG-PNPs and ADR at different concentrations.
3.9.2. Cytotoxicity activity of PG and PG-PNPs on A-549 cell line
Fig. 8 shows the in vitro percentage cell inhibition of PG and PG-PNPs against the human lung cancer cell line (A-549) as compared with the blank PNPs, positive control drug (ADR), and untreated cell line (negative control). This shows remarkable data following the treatment with PG, PG-PNPs, and ADR as controlled drug. against the cell line; hence, considered to be active when compared with the positive drug (ADR. The PG inhibited the proliferation of the cells at tested concentrations as follows A-549 PG-10 μg/ml (90%), PG-20 μg/ml (96%), PG-10 μg/ml (100%), and PG-80 μg/ml (100%) respectively, this activity leads to a significant number of cell reduction with recorded cell rupture, while 40 and 80 μg/ml caused total cell death without cytotoxicity when compared with the effect of Adriamycin control drug in A-549 ADR. Similarly, A-549 PG-PNPs shows the percentage of cell inhibition at 10 μg/ml (48%), 20 μg/ml (61.5%), 40 μg/ml (65%), and 80 μg/ml (68.2%) with significant evidence of cell growth inhibition and death when compared with the ADR and untreated cells. The cell morphologies under the electron microscope in Fig. 8 shows the cell arrest and morphological rupture that lead to cell reduction and growth inhibition by PG and PG-PNPS at different concentrations of 20, 40, and 80 μg/ml. The cells treated with the blank PNP also shows no inhibitory effect on the cell viability with no detectable cytotoxicity by the treatment concentrations. The PG and PG-PNPs shows significant cell inhibition by the reference ADR drug, which suggests there was no apparent cytotoxicity to the epithelial cells of the human airway.
Fig. 8.
The percentag cell inhibition of human A459 lung epithelial cell viability together with cell morphology after exposures with PG, PNPs, PG-PNPs and ADR at different concentrations.
3.9.3. Cytotoxic activity of PG and PG-PNPs on HT-29 cell line
Fig. 9 shows the in vitro percentage cell inhibition of PG and PG-PNPs concentrations at 10, 20, 40, and 80 μg/ml and cell death in human colon cancer cell line (HT-29) as compared with the blank PNPs, ADR positive control drug and untreated cell line (negative control). The PG and PG-PNPs showed activity against the cell line, hence, were considered to be active when compared with the ADR. The PG against HT-29 at 10 μg/ml (81%), 20 μg/ml (85%), 40 μg/ml (93.7%), and 80 μg/ml (100%) concentrations inhibited the proliferation of the cells leading to cell arrest with reference to the effect of ADR at 80 μg/ml (100%). Similarly, PG-PNPs percentage inhibition of HT-29 cells also shows 10 μg/ml (38%), 20 μg/ml (55.3%), 40 μg/ml (67.4%), and 80 μg/ml (78%) as evidence of cell growth inhibition and cell death when compared with the untreated cells. The structural morphology of the HT-29 cell under a confocal microscope in Fig. 8 shows rupture and shrinkage of the HT-29 cell line treated with different concentrations of 10, 20, 40 and 80 μg/ml of both PG, PG-PNPs leading to cell death when compared with the activity of ADR (positive) and untreated cell (negative) controls. For the cells treated with the blank PNPs and untreated cells, there was no inhibitory effect on the cell viability with no detectable cytotoxicity. The PG and PG-PNPs have comparable cell viability to those of reference ADR drugs and blank PNPs, this implies no cytotoxicity to the human colorectal normal cells.
Fig. 9.
The percentage cell inhibition of human HT colon epithelial cell viability together with cell morphology after exposures with PG, PNPs, PG-PNPs and ADR at different concentrations.
4. Discussion
Prodigiosin (PG) in Fig. 1, is a poorly water-soluble compound obtained from bacteria that have shown an inhibitory effect against cancer cells [32]; however, it has not been formulated in any pharmaceutical dosage form. This necessitated the idea of formulating the product into a parenteral nanoparticles dosage form. As shown in Fig. 2, PG gave an amorphous and pinkish powder after formulation and lyophilization and it could be reconstituted before administration through an injectable route. It has been reported that the conversion of a drug to its amorphous form enhances its solubility [33,34]. The %EE and LC of PG-PNPs formulated showed a good entrapment and loading capacity, which is a critical factor in drug and excipients combination [35]. This results in the compatibility of excipients selected for the formulation in accommodating the drug [36].
The FTIR spectra (Fig. 3) revealed there was no chemical interaction occurring as a result of the incorporation of PG into the PNPs formulation. The broad and noticeable peak in the PG spectrum could be due to N–H stretching as well as C–H stretching. Similarly, the C–O stretch produced a peak and also, a noticeable peak ascribed to C–O–C stretching as observed in some earlier reports [37]. Since PG-PNPs shows similar peaks as observed in the PG alone, thereby exhibiting peaks characteristic of the functional groups it contains, it suggests that no chemical interaction or incompatibility occurred between PG and excipients. The 1H NMR spectra of PG, PG-PNPs, PNPs, and complete assigned 1H NMR chemical shift (δ, ppm), are shown in Fig. 3. The δ values were compared with literature data and found to correspond with the 1H NMR data of PG previously isolated from S. violaceusniger [38]. A comparison of the 1H NMR spectra of PG and PG-PNPs showed no significant changes in the δ values of the –CH2-CH2-CH2-CH2- side chain, –NH of the substituted pyrrole rings, the –CH3 (or –OCH3) groups or the olefinic protons of PG, therefore, these imply that there was no significant and observable solid-state interaction of PG-excipients in the formulation.
The overlay DSC thermographs in Fig. 4 show the thermal properties of both PG, PG-PNP and PNP respectively with exothermic and two endothermic area peaks as low crystallinity and amorphous state indicating solubility in an aqueous medium. However, the admixture of the excipients and PG in the PG-PNPs formulation showed an endothermic peak which could result in the melting point of the excipient that relates to excipient-drug thermal interaction for an enhanced solubility of the PG. The PG and PG-PNPs when observed under TEM (Fig. 4), shows PG nanocrystals and PG-PNPs with hexagonal ice crystal formation as well as lipid ice lamella sheet in the PNP. The structural and morphological interaction of PG and excipients compatibility for possible solubility is the effect of intermolecular forces on the physical behaviour of the active substance and excipients [39]. Release kinetics (Fig. 5) showed the in vitro drug release profile of the optimized PG-PNP in phosphate buffer (pH 7.4) which followed the first-order kinetics and sustained the maximum percentage release for 8–12 h indicating a uniform and sustained release, thereby eliminating the possibility of dose dumping when administered.
The effect of one-week treatment studies with PG and PG-PNPs formulation on the hematological parameters of the rats are shown in Fig. 5. Dose-dependent results were obtained from the study on the effects of the PG-PNPs in comparison with those administered with only normal saline. The result showed that the intraperitoneal administration of the PG-PNPs suspension caused an insignificant increase in PCV, possibly as a result of more production of RBC when compared to the normal range of 10–47%. Similarly, the WBC and Hb when compared with the normal, indicated that the PG and PG-PNPS administered were non-toxic to the animal’s hematological parameters evaluated and as such, ensured that the animals maintained non anaemic status throughout the study period. Suuch situation can be caused by RBC destruction or inhibition of haem synthesis in the bone marrow as a result of uremic toxins [40,41]. Recently, nanoparticles have been reported to show an increase in RBC production with an increase in Hb concentration [42]. The RBCs are primarily produced in the bone marrow by haemopoietic stem cells, which are triggered by erythropoietic activity [43]. This indicates that the acute toxicity treatment at a higher concentration of the PG and PG-PNPs formulation could not significantly affect the investigated hematological parameters at a lower concentration. Consequently, from the above effects, there was no significant difference in the values of PCV, HB, RBC and WBC count of both the treated when compared to the untreated groups. The histopathological status of the liver and kidney were examined. The absence of hepatic changes in liver sections of rats following the intraperitoneal administration of PG and PG-PNPs (Fig. 6 A1-5 and 6.0 B1-5), suggests that there was no injury to the architecture of the organ from PG and PG-PNPs post-administration. Furthermore, the normal appearance of the central vein and hepatic sinusoids lined with endothelial and macrophages formed were similar to the controls (Fig. 6 A6). In the groups that received PG, only three animals (Fig. 6 A3-5) had a mild vacuolar change of hepatocytes at the high dose of the drug. Similarly, in the groups that received PG-PNPs, only the liver sections of two animals (Fig. 6 B4 and B5) had just little vacuolar change of hepatocytes which could be a result of an extremely high dose of administration. The hepatocytes of other animals that received lower doses appeared normal in size and shape, and no vacuoles were recorded in their cytoplasm. However, one group (Fig. 6 B4 and B5) showed intra-hepatic hepatocytes and extra-hepatic cholestasis as deposits in the bile canaliculi between the individual hepatocytes were observed which led to the bile retention, indicating induction of cholestasis (biliary stasis). The normal lobular architecture of the liver was not affected; hepatocytes also appeared normal. Besides, there was no treatment-related change in the diameter and appearance of central veins, hepatic sinusoids and portal veins. The liver is a vital organ in the body responsible the for detoxification and metabolism of drugs and other chemical substances for possible utilization and removal through systemic circulation or other excretory mechanisms in the body [44,45]. However, the histopathological and microscopic examination of kidney sections of rats administered with graded doses of PG and PG-PNPs (Fig. 6 A1-5; Fig. 6 B1-5) showed no histopathological injury, nor hepatic changes as compared with the controls. The kidney sections of all the groups showed normal renal medulla and renal cortex comprising the glomerulus (G) and renal tubules with associated interstitial spaces. The renal histopathology of both control and treated groups exhibited normal features with intact glomerular and tubular structures. The capillary tufts and size of the Bowman’s space appeared normal. The kidney is very prominent and responsible for the filtration and excretion of both metabolized and non-metabolized toxic chemicals in the body; kidney tissue cells could be damaged due to much exposition and congestions with noxious materials leading to its lesions [46,47]. However, the proximal convoluted tubules, distal convoluted tubules, collecting tubules, Henle’s loop, macula densa, and mesangial cells appeared normal after administration of both PG and PG-PNPs doses.
The cytotoxicity activity of PG and PG-PNPs (Fig. 7) showed the in vitro percentage cell inhibitions and cell morphologies in the presence of PG and PG-PNPs against triple-negative breast, lung, and colon cancer cells in comparison to blank PNPs, positive control (ADR) and untreated cell line (negative control). Growth inhibition is a quantitative percentage response metrics from a drug concentration needed to inhibit cell proliferation completely or reduce the population by 50% or more [48]. The cell growth inhibition by both ADR and PG indicated that the assay has a higher signal of activity after the addition of drugs. Similarly, the PG and PG-PNPs also demonstrated activity against the MCF-7 cell line at the minimal concentrations tested. This effect confirmed the in vitro activity profile of the PG in the form of a pyrrolidine compound, which has earlier been reported to induce cell death through apoptosis as a major target of action against breast cancer [49]. Similarly, PG has been reported earlier to inhibit Wnt/β-catenin signaling and subsequently, exert cytotoxicity activity against breast cancer cells [50]. It can also induce the control of p53 family-dependent transcription and enhance activity in p53-deficient colon cancer cells [51]. The cell inhibition activity in Fig. 7, shows the MCF-7 breast cancer cell inhibitions and morphological rupture by different concentrations of both PG and PG-PNPs with reference to positive and negative controls. Therefore, the shrinkage of the cells is clear evidence of cell growth inhibition when compared with the untreated cells which corroborates the earlier report on the activity of prodigiosin (PG) against the MCF-7 cell line [52]. Also, Fig. 8 showed the in vitro percentage cell inhibition (growth inhibition) of human lung cancer cell line (A-549) by PG and PG-PNPs as compared with the placebo PNPs, positive control (ADR) and untreated cell line (negative control). The in vitro activity is evidence for the direct coupling of cell cycle related proteins to cytoplasmic pH homeostasis [53]. PG has been reported as a compound that promotes H+ and Cl− symporters which neutralize the acidic compartment of cells, and results in the acidification of the cytoplasm and possibly results in cell cycle inhibition and arrest [54]. The in vitro percentage cell inhibition of PG and PG-PNPs against human colon cancer cell line (HT-29) at different concentrations (Fig. 9) as compared with the PNPs placebo, ADR and untreated cell line (negative control). The PG and PG-PNPs showed activity at various concentrations against the cell line hence, considered to be active when compared with the ADR. The in vitro activity is evidence for the direct coupling of cell cycle related proteins to cytoplasmic pH homeostasis. This is in line with the earlier report of PG inducing neutralization of acidic compartment of cells through ionic symporters, which reactivate activity response of p53 family-dependent transcription in p53-deficient human colon cancer cells resulting in cell death [51]. Subsequently, it acidifies lysosomes, which further induce the cell cycle and block colon cancer cell proliferation [55]. The expressed PG by S. marcescens, in some reports has shown potent biological activities which can help in tackling the increasing rate of cancer problem today which formed the bases and justification of this research. It is an effective proapoptotic agent against breast cancer cell lines (such as triple-negative breast), lung, and colon cancers with multiple cellular targets of multi-drug resistant cells without toxicity.
5. Conclusion
In this study, prodigiosin (PG) was obtained from the bacteria "S. marcescens" and formulated into parenteral nanoparticles targeted against triple-negative breast, lung, and colon cancers. The production of PG was optimized by choosing an appropriate growth medium and optimal growth conditions for the growth of the bacteria. The PG expression by S. marcescens was maximal. The PNP enhanced the poor solubility of PG and showed a remarkably excellent performance in the delivery of the PG which is very novel in pharmaceutical product formulation. Physicochemical characterizations of the formulations confirmed that no chemical interaction occurred after the encapsulation of PG in the PNPs. The toxicity, in vitro cytotoxicity and other biological activities, revealed the potential efficiency of the PG with maximum safety. The outcome of the research promised to be robust, effective, well-targeted, and cheap microbial-sourced anticancer dosage forms for the benefit of low-income patients. The promising anti-cancer properties of PG from microbial source is set to be a veritable solution to the expensive drugs used in the treatment of breast, lung, and colon cancers. The issue of PG solubility in water as a universal solvent is a limitation and challenge, however, the future prospects from the compound activities ensure advancements in choosing appropriate solvents in the delivery of PG without toxicity. There is, therefore, the need for the use of commonly available microbial-based drugs or other natural products to develop alternative and effective cancer therapy to combat the increasing rate and ravaging effect of cancer globally especially in Africa, America, and Europe.
Author contribution statement
Thaddeus Harrison Gugu: Conceived and designed the experiments; Performed the experiments; Analyzed and interpreted the data; Wrote the paper.
Ganesh Dinkarrao Basarkar: Conceived and designed the experiments; Performed the experiments; Contributed reagents, materials, analysis tools or data; Wrote the paper.
Anthony Amaechi Attama, Emmanuel Chinedum Ibezim, Chandrashekhar Devidas Upasani: Conceived and designed the experiments; Contributed reagents, materials, analysis tools or data; Wrote the paper.
Christopher Osita Eze: Performed the experiments; Wrote the paper.
Frankline Chimaobi Kenechukwu: Performed the experiments; Analyzed and interpreted the data; Wrote the paper.
Sanjay Bhivasan Patil: Performed the experiments; Analyzed and interpreted the data; Contributed reagents, materials, analysis tools or data; Wrote the paper.
Muhammd A. Khumaini Mudhar Bintang: Analyzed and interpreted the data; Wrote the paper.
Teerapol Srichana: Analyzed and interpreted the data; Contributed reagents, materials, analysis tools or data; Wrote the paper.
Data availability statement
No data was used for the research described in the article.
Declaration of competing interest
The authors declare that they have no known competing financial interests or personal relationships that could have appeared to influence the work reported in this paper.
Acknowledgment
On behalf of other authors, I wish to thank the University of Nigeria, Nsukka, SNJB’s College of Pharmacy, India, and DDSEC, Prince of Songkhla University, Thailand for providing facilities and enabling environment for us to carry out the research.
Abbreviations
- ADR
Adriamycin
- ATR
Attenuated total reflectance
- Cl−
Chloride ion
- CPCSEA
Committee for the Purpose of Control and Supervision of Experiments on Animals
- DAAD
Deutscher Akademischer Austauschdienst (German Academic Exchange Service)
- DLC
Drug loading capacity
- DLS
Dynamic Light Scattering
- DSC
Differential Scanning Calorimeter
- EE
Entrapment efficiency
- FDA
Food and Drug Administration
- FT-IR
Fourier-transform infrared spectroscopy
- GI
Growth inhibition
- H+
Hydrogen ion
- HB
Haemoglobin
- HER2
Human epidermal growth receptor two
- HT-29
Human colon cancer cell line
- MCF-7
Michigan Cancer Foundation-7
- MDR
Multidrug-resistant
- NIH
National Institutes of Health
- NIPA
N-isopropyl acrylamide
- NMR
Nuclear magnetic resonance
- PCV
Pack cell volume
- PG
Prodigiosin
- PGA
Peptone glycerol agar
- PNP
Parenteral nano-particle
- RBC
Red blood cell
- SPC
Soy phosphatidylcholine
- TCA
Trichloroacetic acid
- TEM
Transmission electron microscopy
- TLC
Thin layer chromatography
- TNBC
Triple-negative breast cancer
- WBC
White blood cell
- ZnSe
Zinc selenide
References
- 1.Global C. Burden of disease cancer, cancer incidence, mortality, years of life lost, years lived with disability, and disability-adjusted life years for 29 cancer groups from 2010 to 2019: a systematic analysis for the global burden of disease study 2019. JAMA Oncol. 2022;8:420–444. doi: 10.1001/jamaoncol.2021.6987. [DOI] [PMC free article] [PubMed] [Google Scholar]
- 2.World Health O. World Health Organization; Geneva: 2022. World Health Statistics 2022: Monitoring Health for the SDGs, Sustainable Development Goals. [Google Scholar]
- 3.Dolle J.M., Daling J.R., White E., Brinton L.A., Doody D.R., Porter P.L., et al. Risk factors for triple-negative breast cancer in women under the age of 45 years. Cancer Epidemiol. Biomarkers Prev. 2009;18:1157–1166. doi: 10.1158/1055-9965.EPI-08-1005. [DOI] [PMC free article] [PubMed] [Google Scholar]
- 4.Dent R., Trudeau M., Pritchard K.I., Hanna W.M., Kahn H.K., Sawka C.A., et al. Triple-negative breast cancer: clinical features and patterns of recurrence. Clin. Cancer Res. 2007;13:4429–4434. doi: 10.1158/1078-0432.CCR-06-3045. [DOI] [PubMed] [Google Scholar]
- 5.Vogelstein B., Kinzler K.W., Kinzler K.W. Medical Pub. Division.; McGraw-Hill: 2002. The Genetic Basis of Human Cancer. [Google Scholar]
- 6.Kumari S., Sharma S., Advani D., Khosla A., Kumar P., Ambasta R.K. Unboxing the molecular modalities of mutagens in cancer. Environ. Sci. Pollut. Control Ser. 2022;29:62111–62159. doi: 10.1007/s11356-021-16726-w. [DOI] [PMC free article] [PubMed] [Google Scholar]
- 7.Oh S.Y., Lee E.J., Sung M.K. Evaluation of plant polyphenols as anti‐inflammatory and anti‐cancer agents. Faseb. J. 2007;21:6. [Google Scholar]
- 8.Gordaliza M. Natural products as leads to anticancer drugs. Clin. Transl. Oncol. 2007;9:767–776. doi: 10.1007/s12094-007-0138-9. [DOI] [PubMed] [Google Scholar]
- 9.Li D., Liu J., Wang X., Kong D., Du W., Li H., et al. Biological potential and mechanism of prodigiosin from Serratia marcescens subsp. lawsoniana in human choriocarcinoma and prostate cancer cell lines. Int. J. Mol. Sci. 2018;19:3465. doi: 10.3390/ijms19113465. [DOI] [PMC free article] [PubMed] [Google Scholar]
- 10.Montaner B., Navarro S., Piqué M., Vilaseca M., Martinell M., Giralt E., et al. Prodigiosin from the supernatant of Serratia marcescens induces apoptosis in haematopoietic cancer cell lines. Br. J. Pharmacol. 2000;131:585–593. doi: 10.1038/sj.bjp.0703614. [DOI] [PMC free article] [PubMed] [Google Scholar]
- 11.Wang Z., Li B., Zhou L., Yu S., Su Z., Song J., et al. Prodigiosin inhibits Wnt/β-catenin signaling and exerts anticancer activity in breast cancer cells. Proc. Natl. Acad. Sci. USA. 2016;113:13150–13155. doi: 10.1073/pnas.1616336113. [DOI] [PMC free article] [PubMed] [Google Scholar]
- 12.Darshan N., Manonmani H.K. Prodigiosin, and its potential applications. J. Food Sci. Technol. 2015;52:5393–5407. doi: 10.1007/s13197-015-1740-4. [DOI] [PMC free article] [PubMed] [Google Scholar]
- 13.D'Alessio R., Bargiotti A., Carlini O., Colotta F., Ferrari M., Gnocchi P., et al. Synthesis and immunosuppressive activity of novel prodigiosin derivatives. J. Med. Chem. 2000;43:2557–2565. doi: 10.1021/jm001003p. [DOI] [PubMed] [Google Scholar]
- 14.Arivizhivendhan K.V., Mahesh M., Boopathy R., Swarnalatha S., Regina Mary R., Sekaran G. Antioxidant and antimicrobial activity of bioactive prodigiosin produces from Serratia marcescens using agricultural waste as a substrate. J. Food Sci. Technol. 2018;55:2661–2670. doi: 10.1007/s13197-018-3188-9. [DOI] [PMC free article] [PubMed] [Google Scholar]
- 15.Lapenda J.C., Silva P.A., Vicalvi M.C., Sena K.X., Nascimento S.C. Antimicrobial activity of prodigiosin isolated from Serratia marcescens UFPEDA 398. World J. Microbiol. Biotechnol. 2015;31:399–406. doi: 10.1007/s11274-014-1793-y. [DOI] [PubMed] [Google Scholar]
- 16.Khanafari A., Assadi M.M., Fakh F.A. RETRACTED: review of prodigiosin, pigmentation in Serratia marcescens. Online J. Biol. Sci. 2006;6:1. [Google Scholar]
- 17.Demain A.L., Fang A. The natural functions of secondary metabolites. Adv. Biochem. Eng. Biotechnol. 2000;69:1–39. doi: 10.1007/3-540-44964-7_1. [DOI] [PubMed] [Google Scholar]
- 18.Hu D.X., Withall D.M., Challis G.L., Thomson R.J. Structure, chemical synthesis, and biosynthesis of prodiginine natural products. Chem. Rev. 2016;116:7818–7853. doi: 10.1021/acs.chemrev.6b00024. [DOI] [PMC free article] [PubMed] [Google Scholar]
- 19.Williamson N.R., Fineran P.C., Leeper F.J., Salmond G.P. The biosynthesis and regulation of bacterial prodiginines. Nat. Rev. Microbiol. 2006;4:887–899. doi: 10.1038/nrmicro1531. [DOI] [PubMed] [Google Scholar]
- 20.Mo S., Sydor P.K., Corre C., Alhamadsheh M.M., Stanley A.E., Haynes S.W., et al. Elucidation of the Streptomyces coelicolor pathway to 2-undecylpyrrole, a key intermediate in undecylprodiginine and streptorubin B biosynthesis. Chem. Biol. 2008;15:137–148. doi: 10.1016/j.chembiol.2007.11.015. [DOI] [PubMed] [Google Scholar]
- 21.Fürstner A., Grabowski J., Lehmann C.W., Kataoka T., Nagai K. Synthesis and biological evaluation of nonylprodigiosin and macrocyclic prodigiosin analogues. Chembiochem. 2001;2:60–68. doi: 10.1002/1439-7633(20010105)2:1<60::AID-CBIC60>3.0.CO;2-P. [DOI] [PubMed] [Google Scholar]
- 22.Persi E., Duran-Frigola M., Damaghi M., Roush W.R., Aloy P., Cleveland J.L., et al. Systems analysis of intracellular pH vulnerabilities for cancer therapy. Nat. Commun. 2018;9:2997. doi: 10.1038/s41467-018-05261-x. [DOI] [PMC free article] [PubMed] [Google Scholar]
- 23.Ogrunc M., Di Micco R., Liontos M., Bombardelli L., Mione M., Fumagalli M., et al. Oncogene-induced reactive oxygen species fuel hyperproliferation and DNA damage response activation. Cell Death Differ. 2014;21:998–1012. doi: 10.1038/cdd.2014.16. [DOI] [PMC free article] [PubMed] [Google Scholar]
- 24.Anwar M.M., Albanese C., Hamdy N.M., Sultan A.S. Rise of the natural red pigment ‘prodigiosin’ as an immunomodulator in cancer. Cancer Cell Int. 2022;22:419. doi: 10.1186/s12935-022-02815-4. [DOI] [PMC free article] [PubMed] [Google Scholar]
- 25.Danyuo Y., Dozie-Nwachukwu S., Obayemi J.D., Ani C.J., Odusanya O.S., Oni Y., et al. Swelling of poly(N-isopropylacrylamide) P(NIPA)-based hydrogels with bacterial-synthesized prodigiosin for localized cancer drug delivery. Mater Sci. Eng. C Mater Biol. Appl. 2016;59:19–29. doi: 10.1016/j.msec.2015.09.090. [DOI] [PubMed] [Google Scholar]
- 26.Xu X., Liu Y., Fu W., Yao M., Ding Z., Xuan J., et al. Poly(N-isopropylacrylamide)-Based thermoresponsive composite hydrogels for biomedical applications. Polymers. 2020;12 doi: 10.3390/polym12030580. [DOI] [PMC free article] [PubMed] [Google Scholar]
- 27.Pardridge W.M. Drug transport across the blood-brain barrier. J. Cerebr. Blood Flow Metabol. 2012;32:1959–1972. doi: 10.1038/jcbfm.2012.126. [DOI] [PMC free article] [PubMed] [Google Scholar]
- 28.Gugu T.H., Chime S.A., Attama A.A. Solid lipid microparticles: an approach for improving oral bioavailability of aspirin. Asian J. Pharm. Sci. 2015;10:425–432. [Google Scholar]
- 29.Attama A.A., Umeyor C.E. The use of solid lipid nanoparticles for sustained drug release. Ther. Deliv. 2015;6:669–684. doi: 10.4155/tde.15.23. [DOI] [PubMed] [Google Scholar]
- 30.Vichai V., Kirtikara K. Sulforhodamine B colorimetric assay for cytotoxicity screening. Nat. Protoc. 2006;1:1112–1116. doi: 10.1038/nprot.2006.179. [DOI] [PubMed] [Google Scholar]
- 31.Skehan P., Storeng R., Scudiero D., Monks A., McMahon J., Vistica D., et al. New colorimetric cytotoxicity assay for anticancer-drug screening. J. Natl. Cancer Inst. 1990;82:1107–1112. doi: 10.1093/jnci/82.13.1107. [DOI] [PubMed] [Google Scholar]
- 32.Bratton S.B., Salvesen G.S. Regulation of the apaf-1-caspase-9 apoptosome. J. Cell Sci. 2010;123:3209–3214. doi: 10.1242/jcs.073643. [DOI] [PMC free article] [PubMed] [Google Scholar]
- 33.Murshedkav T. University of Rhode Island; Kingston, RI: 2002. Effect of Crystalline to Amorphous Conversions on Solubility of Cefuroxime Axetil. [Google Scholar]
- 34.Kanaujia P., Poovizhi P., Ng W.K., Tan R.B.H. Amorphous formulations for dissolution and bioavailability enhancement of poorly soluble APIs. Powder Technol. 2015;285:2–15. [Google Scholar]
- 35.Umeyor E.C., Kenechukwu F.C., Ogbonna J.D., Chime S.A., Attama A. Preparation of novel solid lipid microparticles loaded with gentamicin and its evaluation in vitro and in vivo. J. Microencapsul. 2012;29:296–307. doi: 10.3109/02652048.2011.651495. [DOI] [PubMed] [Google Scholar]
- 36.S.B. Vepuri, S. Anbazhagan, D. Divya, and D.J.I.J.O.P. Padmini . 2013. A Review on Supramolecular Chemistry in Drug Design and Formulation Research; pp. 131–150. [Google Scholar]
- 37.Coates J. In: Encyclopedia of Analytical Chemistry. Meyers R.A., editor. John Wiley & Sons, Ltd; Chichester, UK: 2006. Interpretation of infrared spectra, A practical approach; p. a5606. [Google Scholar]
- 38.Valente A., Boffo E., Ferreira A., Costa F., Melo F., Melo I. Complete NMR Assignments of a new Prodigiosin isolated from Streptomyces violaceusniger violaceusniger. Annals Magnet. Resonance. 2008:7. [Google Scholar]
- 39.Friedrich I., Müller-Goymann C.C. Characterization of solidified reverse micellar solutions (SRMS) and production development of SRMS-based nanosuspensions. Eur. J. Pharm. Biopharm. : Official J. Arbeitsgemeinschaft fur Pharmazeutische Verfahrenstechnik e.V. 2003;56:111–119. doi: 10.1016/s0939-6411(03)00043-2. [DOI] [PubMed] [Google Scholar]
- 40.I. Naeshiro, Y. Ishimura, F. Chatani, and S.M.J.C.H.I. Sato . vol. 7. 1997. Possible Mechanism for the Anaemia Induced by Gentamicin in Rats; pp. 220–225. [Google Scholar]
- 41.Hamza E., Metzinger L., Metzinger-Le Meuth V. Uremic toxins affect erythropoiesis during the course of chronic kidney disease: a review. Cells. 2020;9:2039. doi: 10.3390/cells9092039. [DOI] [PMC free article] [PubMed] [Google Scholar]
- 42.Magaye R.R., Yue X., Zou B., Shi H., Yu H., Liu K., et al. Acute toxicity of nickel nanoparticles in rats after intravenous injection. Int. J. Nanomed. 2014;9:1393–1402. doi: 10.2147/IJN.S56212. [DOI] [PMC free article] [PubMed] [Google Scholar]
- 43.Zhang X.D., Wu H.Y., Wu D., Wang Y.Y., Chang J.H., Zhai Z.B., et al. Toxicologic effects of gold nanoparticles in vivo by different administration routes. Int. J. Nanomed. 2010;5:771–781. doi: 10.2147/IJN.S8428. [DOI] [PMC free article] [PubMed] [Google Scholar]
- 44.Kulsharova G., Kurmangaliyeva A. Liver microphysiological platforms for drug metabolism applications. Cell Prolif. 2021;54 doi: 10.1111/cpr.13099. [DOI] [PMC free article] [PubMed] [Google Scholar]
- 45.Choi Y.Y., Seok J.I., Kim D.S. Flow-based three-dimensional Co-culture Model for long-term hepatotoxicity prediction. Micromachines. 2019;11 doi: 10.3390/mi11010036. [DOI] [PMC free article] [PubMed] [Google Scholar]
- 46.LaFavers K. Disruption of kidney-immune system crosstalk in sepsis with acute kidney injury: lessons learned from animal models and their application to human health. Int. J. Mol. Sci. 2022;23 doi: 10.3390/ijms23031702. [DOI] [PMC free article] [PubMed] [Google Scholar]
- 47.Moghimi S.M., Hunter A.C., Murray J.C. Long-circulating and target-specific nanoparticles: theory to practice. Pharmacol. Rev. 2001;53:283–318. [PubMed] [Google Scholar]
- 48.Heiser L.M., Sadanandam A., Kuo W.-L., Benz S.C., Goldstein T.C., Ng S., et al. Subtype and pathway specific responses to anticancer compounds in breast cancer. Proc. Natl. Acad. Sci. USA. 2012;109:2724–2729. doi: 10.1073/pnas.1018854108. [DOI] [PMC free article] [PubMed] [Google Scholar]
- 49.Hati S., Tripathy S., Dutta P.K., Agarwal R., Srinivasan R., Singh A., et al. Spiro[pyrrolidine-3, 3′-oxindole] as potent anti-breast cancer compounds: their design, synthesis, biological evaluation and cellular target identification. Sci. Rep. 2016;6 doi: 10.1038/srep32213. [DOI] [PMC free article] [PubMed] [Google Scholar]
- 50.Wang Z., Li B., Zhou L., Yu S., Su Z., Song J., et al. Prodigiosin inhibits Wnt/β-catenin signaling and exerts anticancer activity in breast cancer cells. Proc. Natl. Acad. Sci. U. S. A. 2016;113:13150–13155. doi: 10.1073/pnas.1616336113. [DOI] [PMC free article] [PubMed] [Google Scholar]
- 51.Hong B., Prabhu V.V., Zhang S., van den Heuvel A.P., Dicker D.T., Kopelovich L., et al. Prodigiosin rescues deficient p53 signaling and antitumor effects via upregulating p73 and disrupting its interaction with mutant p53. Cancer Res. 2014;74:1153–1165. doi: 10.1158/0008-5472.CAN-13-0955. [DOI] [PMC free article] [PubMed] [Google Scholar]
- 52.Lapenda J.C.L., Alves V.P., Adam M.L., Rodrigues M.D., Nascimento S.C. Cytotoxic effect of prodigiosin, natural red pigment, isolated from Serratia marcescens UFPEDA 398. Indian J. Microbiol. 2020;60:182–195. doi: 10.1007/s12088-020-00859-6. [DOI] [PMC free article] [PubMed] [Google Scholar]
- 53.Songia S., Mortellaro A., Taverna S., Fornasiero C., Scheiber E.A., Erba E., et al. Characterization of the new immunosuppressive drug undecylprodigiosin in human lymphocytes: retinoblastoma protein, cyclin-dependent kinase-2, and cyclin-dependent kinase-4 as molecular targets. J. Immunol. 1997;158:3987–3995. [PubMed] [Google Scholar]
- 54.Sato T., Konno H., Tanaka Y., Kataoka T., Nagai K., Wasserman H.H., et al. Prodigiosins as a new group of H+/Cl- symporters that uncouple proton translocators. J. Biol. Chem. 1998;273:21455–21462. doi: 10.1074/jbc.273.34.21455. [DOI] [PubMed] [Google Scholar]
- 55.Castillo-Avila W., Abal M., Robine S., Pérez-Tomás R. Non-apoptotic concentrations of prodigiosin (H+/Cl- symporter) inhibit the acidification of lysosomes and induce cell cycle blockage in colon cancer cells. Life Sci. 2005;78:121–127. doi: 10.1016/j.lfs.2005.04.059. [DOI] [PubMed] [Google Scholar]
Associated Data
This section collects any data citations, data availability statements, or supplementary materials included in this article.
Data Availability Statement
No data was used for the research described in the article.